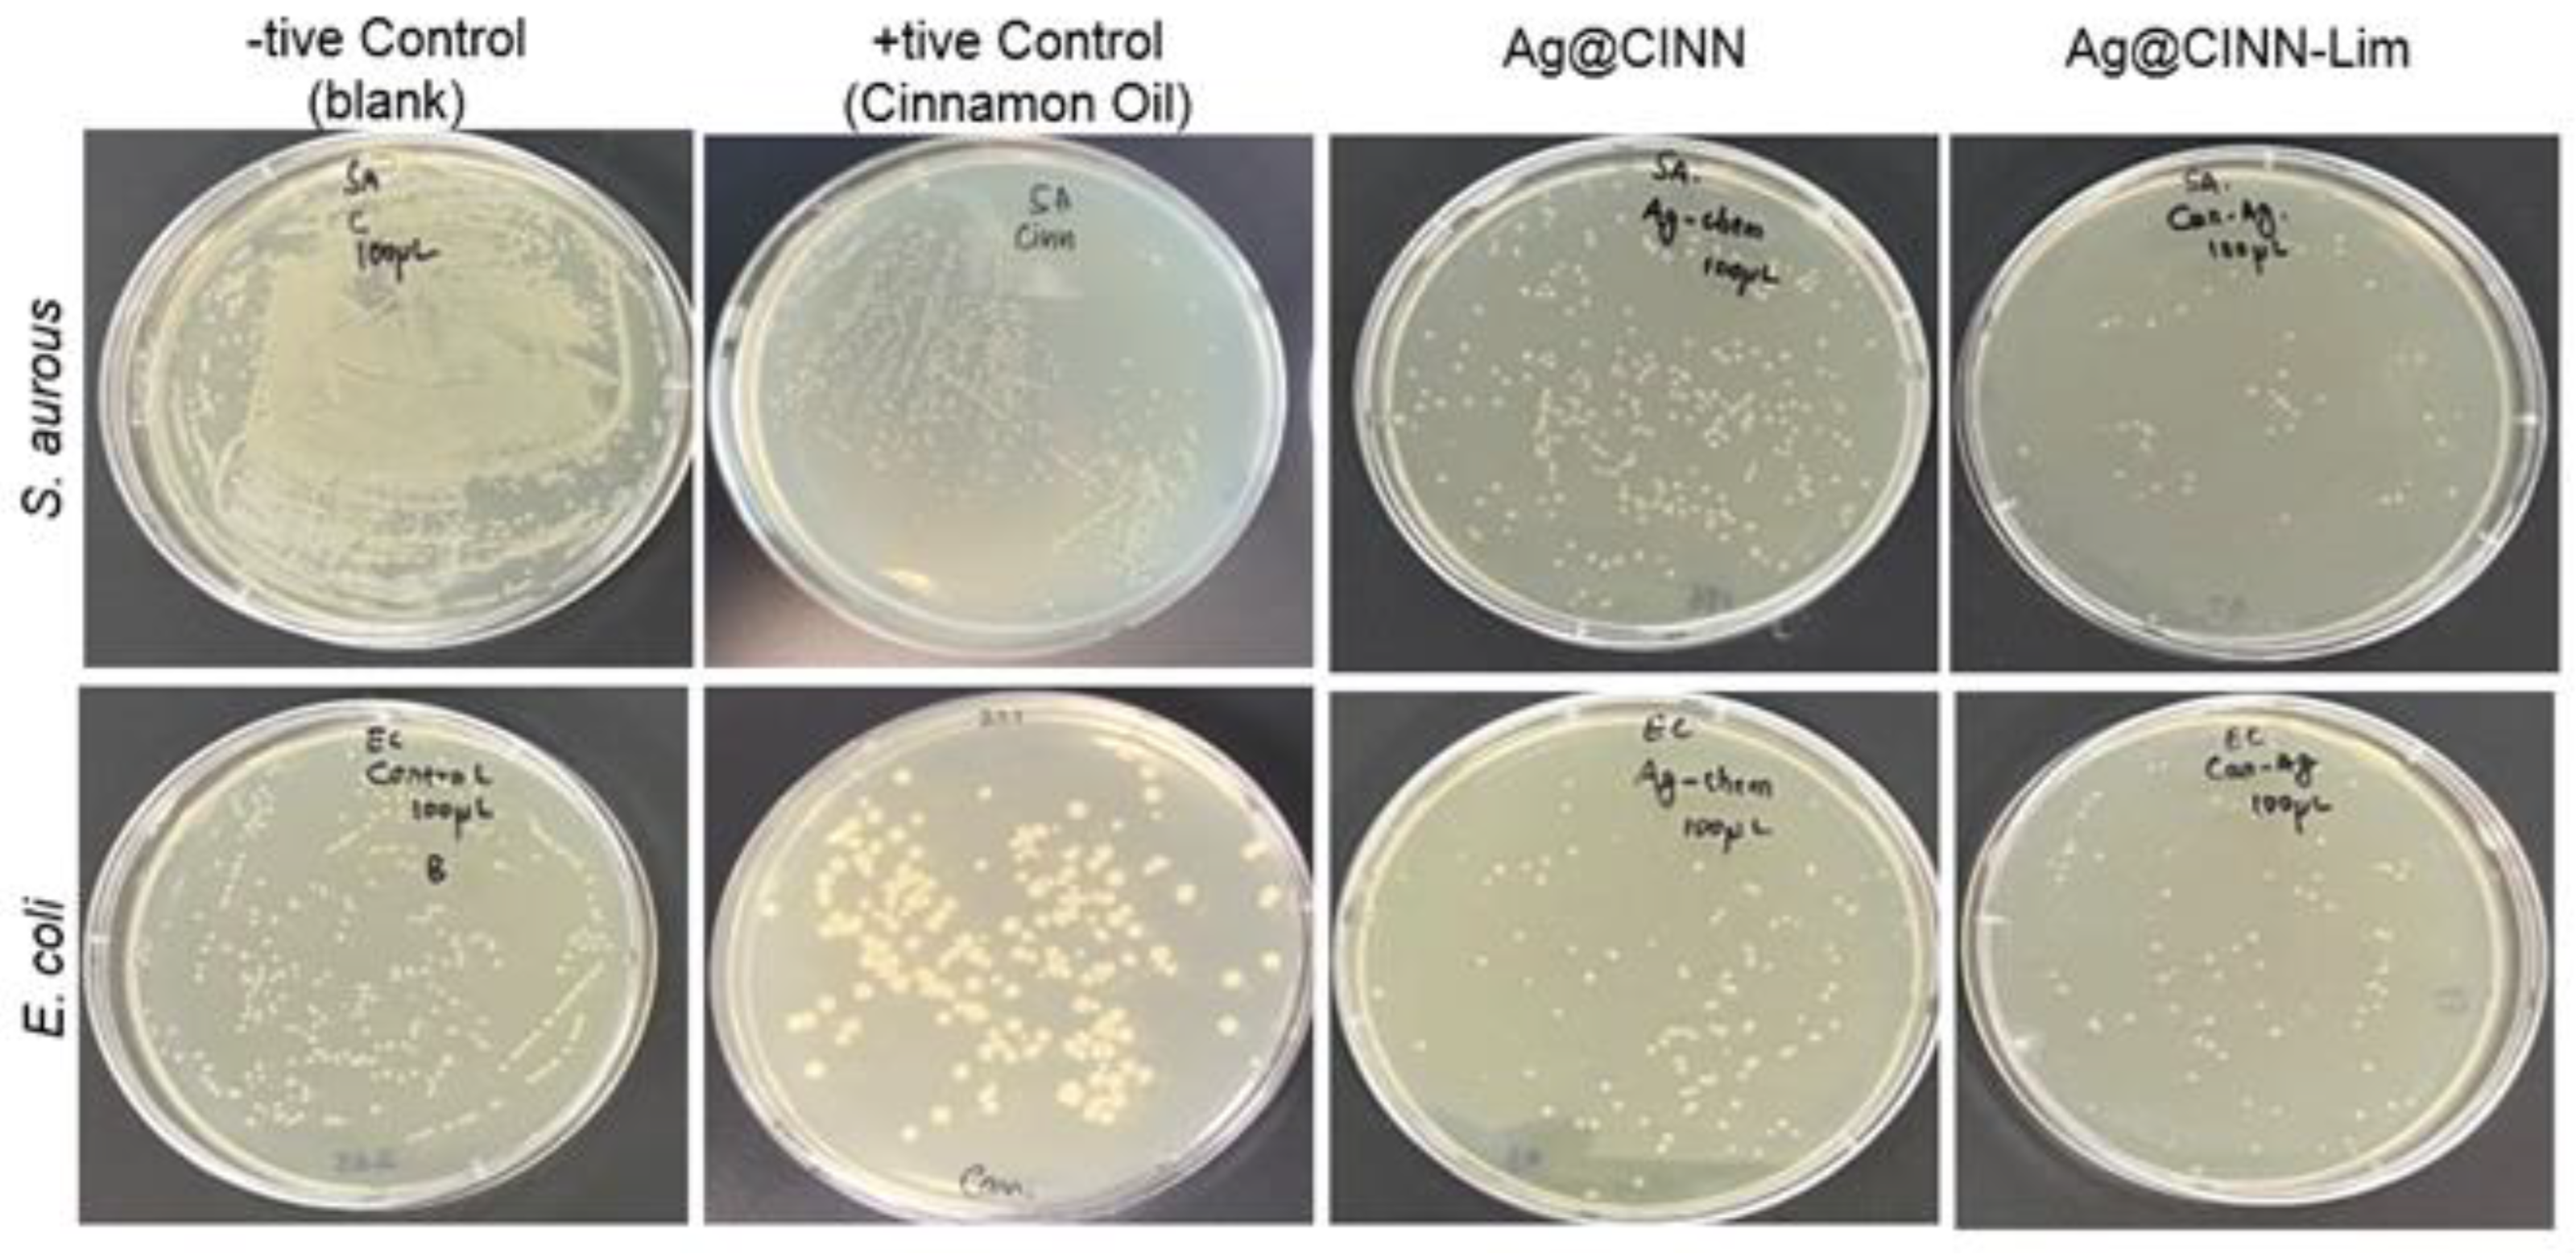
Molecules 28 02802 g004
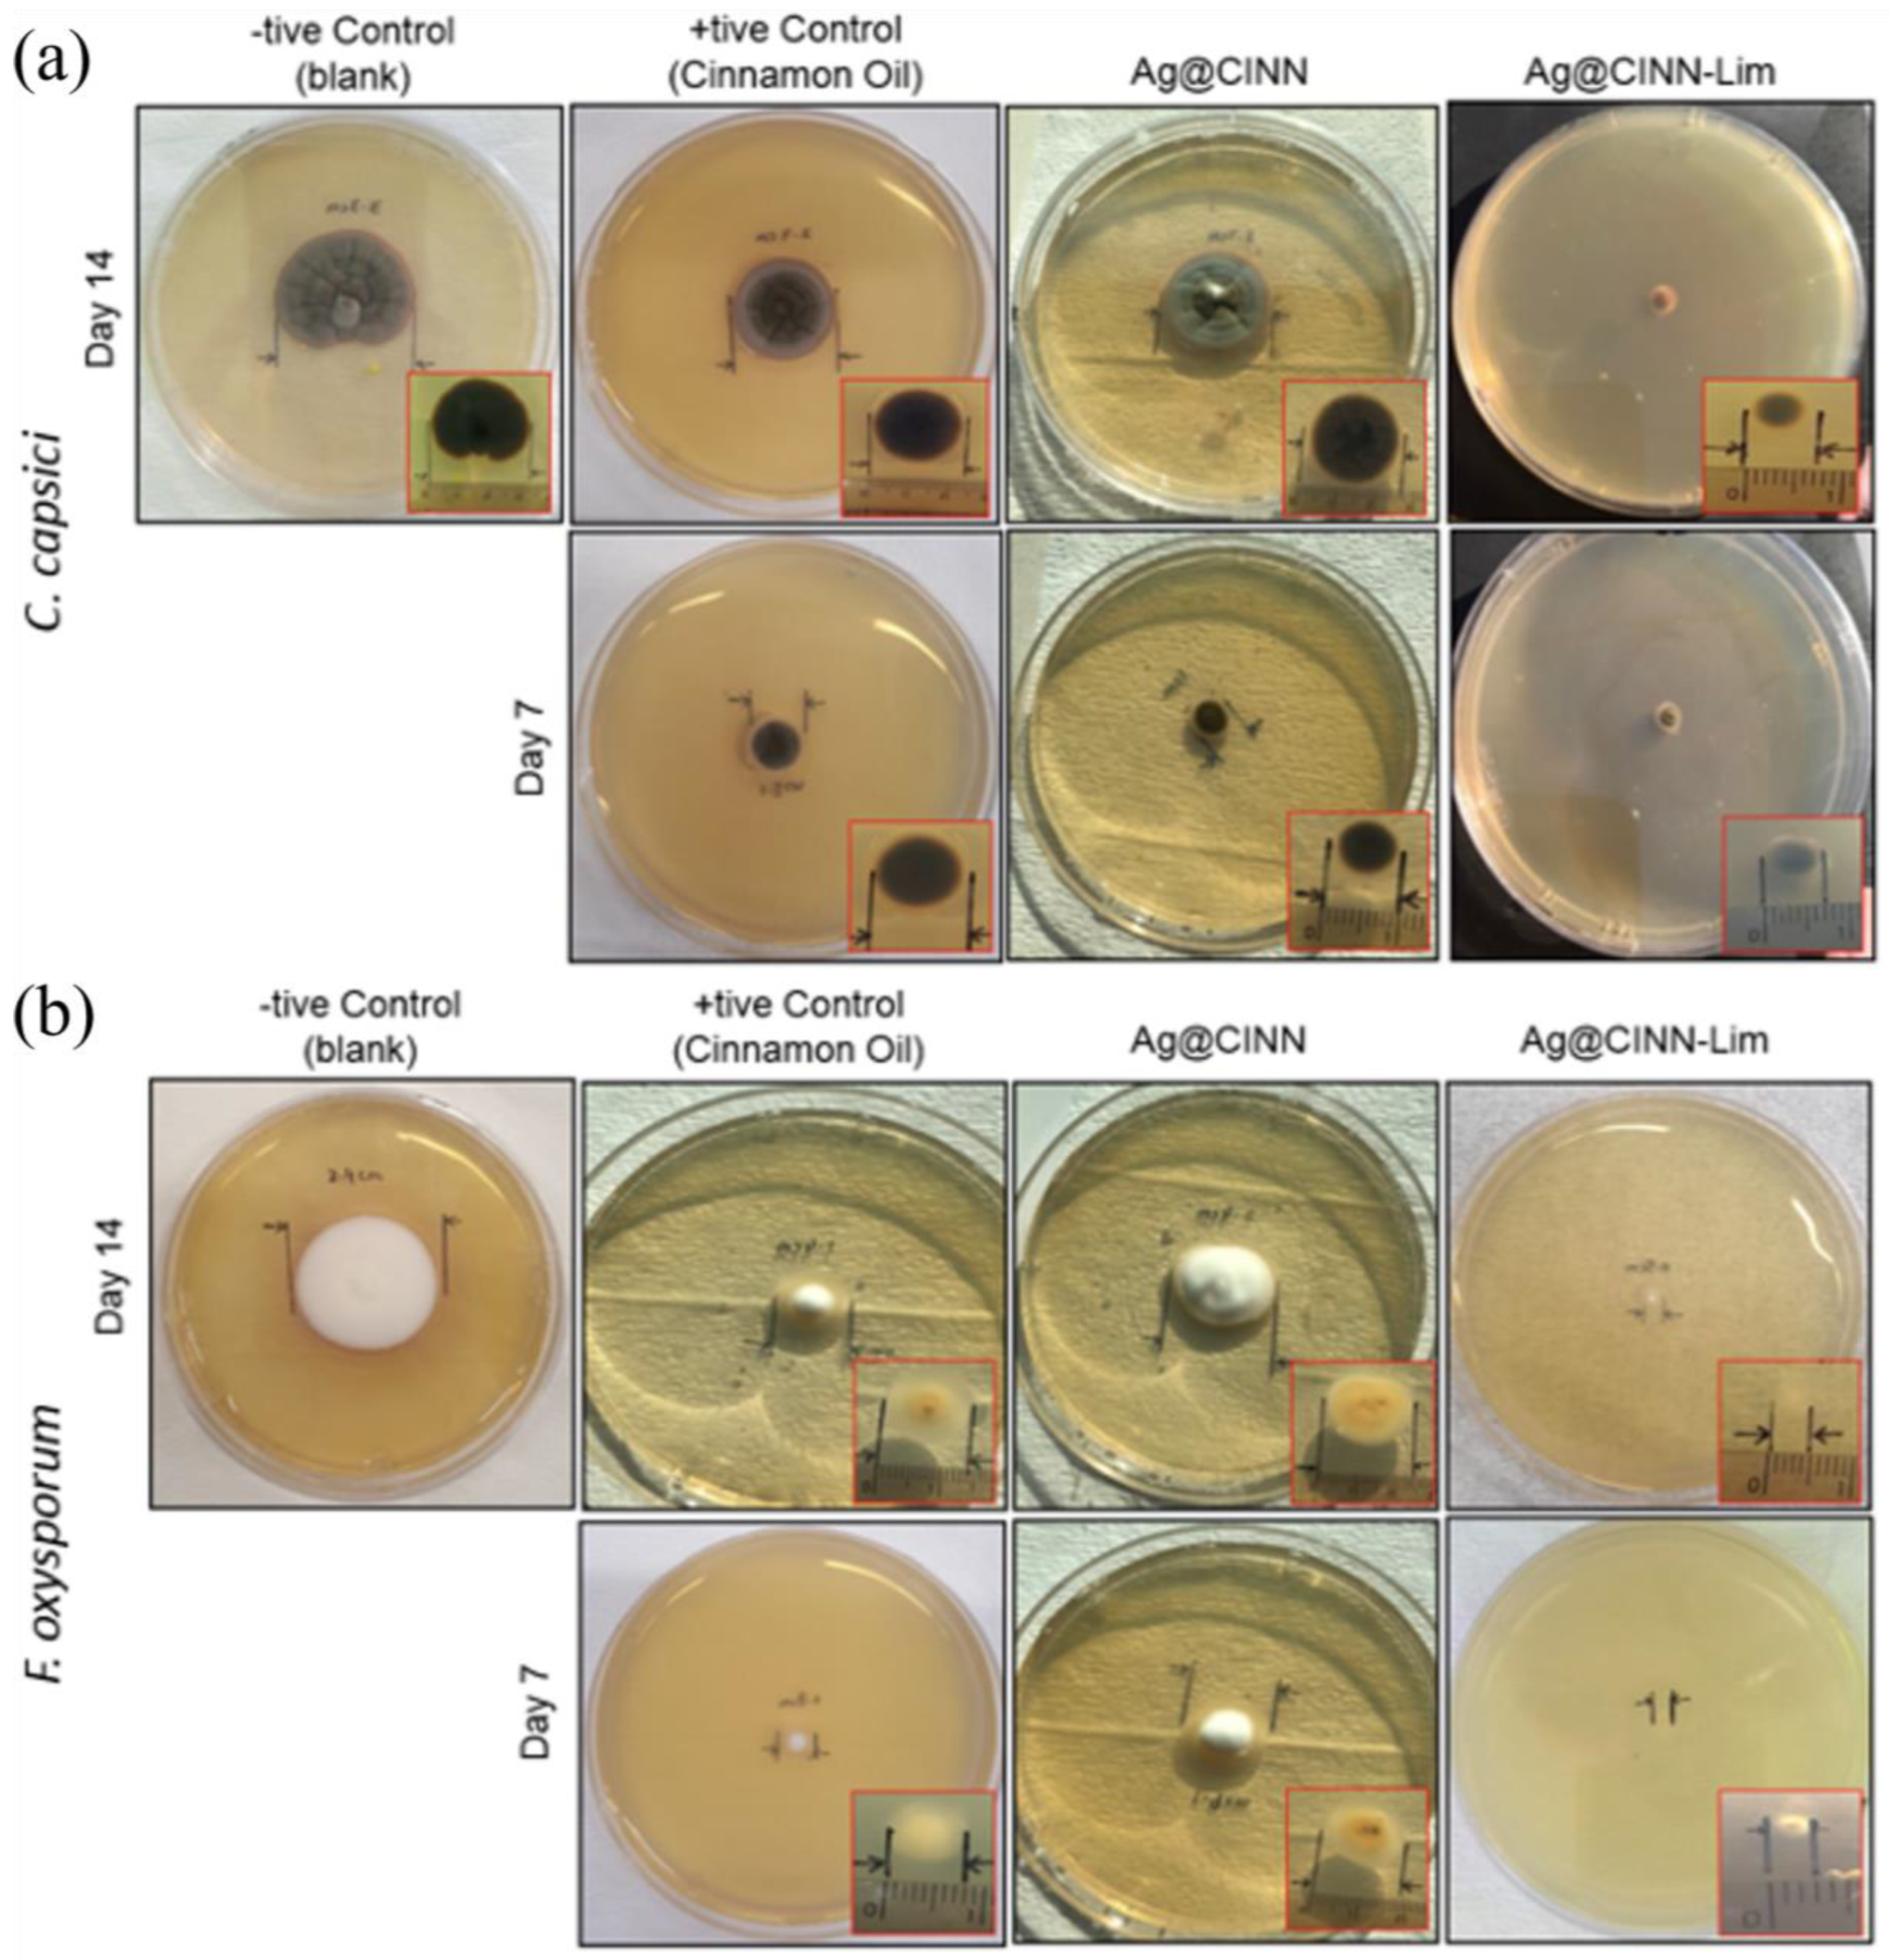
Molecules 28 02802 g006

Citrous Lime—A Functional Reductive Booster for Oil-Mediated Green Synthesis of Bioactive Silver Nanospheres for Healthcare Clothing Applications and Their Eco-Mapping with SDGs
Abstract
1. Introduction
2. Results and Discussion
2.1. UV Adsorption Spectroscopy, SEM, and EDX Measurements
2.2. FTIR Spectroscopic Characterization
2.3. The X-ray Diffraction (XRD) Characterization
2.4. Raman Spectra Characterization
2.5. The Anti-Bacterial Activity Testing
2.6. The Anti-Fungal Activity Testing
2.7. Assessment of Fabric Functional Performance and Eco-Mapping
3. Material and Methods
3.1. Materials
3.2. Methods
3.2.1. Preparation of Ag-NPs
3.2.2. Characterizations of Ag-NPs
3.3. Antimicrobial Assessment
3.4. Antifungal Assessment
3.5. Crease Recovery and Tear Strength Assessment
4. Conclusions
Supplementary Materials
Author Contributions
Funding
Institutional Review Board Statement
Informed Consent Statement
Data Availability Statement
Conflicts of Interest
References
- Ma, J.; Li, K.; Gu, S.; Wu, Y.; Zhang, J.; Wu, J.; Zhao, L.; Li, X. Antimicrobial carbon-dot–stabilized silver nanoparticles. New J. Chem. 2022, 46, 2546–2552. [Google Scholar]
- Filipowska, B.; Rybicki, E.; Walawska, A.; Matyjas-Zgondek, E. New Method for the Antibacterial and Antifungal Modification of Silver Finished Textiles. Fibres Text. East. Eur. 2011, 19, 124–128. [Google Scholar]
- Kędziora, A.; Wieczorek, R.; Speruda, M.; Matolínová, I.; Goszczyński, T.M.; Litwin, I.; Matolín, V.; Bugla-Płoskońska, G. Comparison of Antibacterial Mode of Action of Silver Ions and Silver Nanoformulations With Different Physico-Chemical Properties: Experimental and Computational Studies. Front. Microbiol. 2021, 12. [Google Scholar] [CrossRef] [PubMed]
- Zhang, J.; Klepac, P.; Read, J.M.; Rosello, A.; Wang, X.; Lai, S.; Li, M.; Song, Y.; Wei, Q.; Jiang, H.; et al. Patterns of human social contact and contact with animals in Shanghai, China. Sci. Rep. 2019, 9, 15141. [Google Scholar] [CrossRef] [PubMed]
- Ishida, T. Antibacterial mechanism of Ag+ ions for bacteriolyses of bacterial cell walls via peptidoglycan autolysins, and DNA damages. MOJ Toxicol. 2018, 4, 345–350. [Google Scholar] [CrossRef]
- Ahmed, B.; Ameen, F.; Rizvi, A.; Ali, K.; Sonbol, H.; Zaidi, A.; Khan, M.S.; Musarrat, J. Destruction of Cell Topography, Morphology, Membrane, Inhibition of Respiration, Biofilm Formation, and Bioactive Molecule Production by Nanoparticles of Ag, ZnO, CuO, TiO2, and Al2O3 toward Beneficial Soil Bacteria. ACS Omega 2020, 5, 7861–7876. [Google Scholar] [CrossRef]
- Balakumaran, M.D.; Ramachandran, R.; Jagadeeswari, S.; Kalaichelvan, P.T. In vitro biological properties and characterization of nanosilver coated cotton fabrics–An application for antimicrobial textile finishing. Int. Biodeterior. Biodegrad. 2016, 107, 48–55. [Google Scholar] [CrossRef]
- Mohsin, M.; Ramzan, N.; Quatab, H.G.; Ahmad, S.W.; Sarwar, N. Synthesis of halogen and formaldehyde free bio based fire retardant for cotton. Ind. Text. 2017, 68, 221–225. [Google Scholar] [CrossRef]
- Saxena, S.; Raja, A.S.M.; Arputharaj, A. Challenges in Sustainable Wet Processing of Textiles. Available online: http://www.springer.com/cda/content/document/cda_downloaddocument/9789811021848-c2.pdf?SGWID=0-0-45-1584721-p180182083 (accessed on 19 September 2016).
- Kim, J.; Yun, C.; Park, Y.; Park, C.H. Post-consumer energy consumption of textile products during ‘use’ phase of the lifecycle. Fiber. Polym. 2015, 16, 926. [Google Scholar] [CrossRef]
- Shaheen, T.I.; El Aty, A.A.A. In-situ green myco-synthesis of silver nanoparticles onto cotton fabrics for broad spectrum antimicrobial activity. Int. J. Biol. Macromol. 2018, 118, 2121. [Google Scholar] [CrossRef]
- Kohsari, I.; Shariatinia, Z.; Pourmortazavi, S.M. Antibacterial electrospun chitosan-polyethylene oxide nanocomposite mats containing bioactive silver nanoparticles. Carbohydr. Polym. 2016, 140, 287. [Google Scholar] [CrossRef] [PubMed]
- Ratnasari, A.; Endarko, E.; Syafiuddin, A. A Green Method for the Enhancement of Antifungal Properties of Various Textiles Functionalized with Silver Nanoparticles. Biointerface Res. Appl. Chem. 2020, 10, 7284–7294. [Google Scholar]
- Burda, C.; Chen, X.; Narayanan, R.; El-Sayed, M.A. Chemistry and Properties of Nanocrystals of Different Shapes. Chem. Rev. 2005, 105, 1025. [Google Scholar] [CrossRef] [PubMed]
- Jiang, X.C.; Chen, C.Y.; Chen, W.M.; Yu, A.B. Role of Citric Acid in the Formation of Silver Nanoplates through a Synergistic Reduction Approach. Langmuir 2010, 26, 4400–4408. [Google Scholar] [CrossRef] [PubMed]
- Prathna, T.C.; Chandrasekaran, N.; Raichur, A.M.; Mukherjee, A. Biomimetic Synthesis of Silver Nanoparticles by Citrus limon (Lemon) Aqueous Extract and Theoretical Prediction of Particle Size. Colloids Surf. B Biointerfaces 2011, 82, 152–159. [Google Scholar] [CrossRef]
- Qiu, Z.; Tang, D. Nanostructure-based photoelectrochemical sensing platforms for biomedical applications. J. Mater. Chem. B. 2020, 8, 2541. [Google Scholar] [CrossRef]
- Rana, A.; Yadav, K.; Jagadevan, S. A comprehensive review on green synthesis of nature-inspired metal nanoparticles: Mechanism, application and toxicity. J. Clean. Prod. 2020, 272, 122880. [Google Scholar] [CrossRef]
- Narayanan, K.B.; Sakthivel, N. Biological synthesis of metal nanoparticles by microbes. Adv. Colloid Interface Sci. 2010, 156, 1. [Google Scholar] [CrossRef]
- Menazea, A.A.; Ismail, A.M.; Awwad, N.S.; Ibrahium, H.A. Physical characterization and antibacterial activity of PVA/Chitosan matrix doped by selenium nanoparticles prepared via one-pot laser ablation route. J. Mater. Res. Technol. 2020, 9, 9598–9606. [Google Scholar] [CrossRef]
- Cao, X.; Zhu, L.; Bai, Y.; Li, F.; Yu, X. Green one-step synthesis of silver nanoparticles and their biosafety and antibacterial properties. Green. Chem. Lett. Rev. 2022, 15, 28–34. [Google Scholar] [CrossRef]
- Thanh, N.T.K.; Maclean, N.; Mahiddine, S. Mechanisms of nucleation and growth of nanoparticles in solution. Chem. Rev. 2014, 114, 7610. [Google Scholar] [CrossRef] [PubMed]
- Li, D.; Kaner, R.B. Shape and Aggregation Control of Nanoparticles: Not Shaken, Not Stirred. J. Am. Chem. Soc. 2006, 128, 968–975. [Google Scholar] [CrossRef] [PubMed]
- Er, M. Synthesis of Silver Nanoparticles Using a Plasma-Liquid Process. Ph.D. Thesis, Université Sorbonne Paris Cité, Paris, France, 16 July 2020. [Google Scholar]
- Gawande, M.B.; Shelke, S.N.; Zboril, R.; Varma, R.S. Microwave-Assisted Chemistry: Synthetic Applications for Rapid Assembly of Nanomaterials and Organics. Acc. Chem. Res. 2014, 47, 1338–1348. [Google Scholar] [CrossRef] [PubMed]
- Nadagouda, M.N.; Speth, T.F.; Varma, R.S. Microwave-Assisted Green Synthesis of Silver Nanostructures. Acc. Chem. Res. 2011, 44, 469–478. [Google Scholar] [CrossRef] [PubMed]
- Adhikari, L.; Larm, N.E.; Bhawawet, N.; Baker, G.A. Rapid Microwave-Assisted Synthesis of Silver Nanoparticles in a Halide-Free Deep Eutectic Solvent. ACS Sustain. Chem. Eng. 2018, 6, 5725–5731. [Google Scholar] [CrossRef]
- Iravani, S.; Korbekandi, H.; Mirmohammadi, S.; Zolfaghari, B. Synthesis of silver nanoparticles: Chemical, physical and biological methods. Res. Pharm. Sci. 2014, 9, 385–406. [Google Scholar]
- Heuer-Jungemann, A.; Feliu, N.; Bakaimi, I.; Hamaly, M.; Alkilany, A.; Chakraborty, I.; Masood, A.; Casula, M.F.; Kostopoulou, A.; Oh, E.; et al. The Role of Ligands in the Chemical Synthesis and Applications of Inorganic Nanoparticles. Chem. Rev. 2019, 119, 4819. [Google Scholar] [CrossRef]
- de Oliveira Brisola Maciel, M.V.; da Rosa Almeida, A.; Machado, M.H.; Elias, W.C.; da Rosa, C.G.; Teixeira, G.L.; Noronha, C.M.; Bertoldi, F.C.; Nunes, M.R.; de Armas, R.D.; et al. Green synthesis, characteristics and antimicrobial activity of silver nanoparticles mediated by essential oils as reducing agents. Biocatal. Agric. Biotechnol. 2020, 28, 101746. [Google Scholar] [CrossRef]
- Haddi, K.; Faroni, L.R.A.; Oliveira, E.E. Green Pesticides Handbook; Taylor & Francis: Abingdon: UK; CRC Press: Boca Raton, FL, USA, 2017; pp. 117–150. [Google Scholar]
- Ali, B.; Al-Wabel, N.A.; Shams, S.; Ahamad, A.; Khan, S.A.; Anwar, F. Essential oils used in aromatherapy: A systemic review. Asian Pac. J. Trop. Biomed. 2015, 5, 601–611. [Google Scholar] [CrossRef]
- Shang, C.; Lin, H.; Fang, X.; Wang, Y.; Jiang, Z.; Qu, Y.; Xiang, M.; Shen, Z.; Xin, L.; Lu, Y.; et al. Beneficial effects of cinnamon and its extracts in the management of cardiovascular diseases and diabetes. Food Funct. 2021, 12, 12194–12220. [Google Scholar] [CrossRef]
- Hosseinnezhad, M.; Gharanjig, K.; Razani, N.; Imani, H. Green Dyeing of Wool Fibers with Madder: Study of Combination of Two Biomordant on K/S and Fastness. Fibers Polym. 2020, 21, 2036–2041. [Google Scholar] [CrossRef]
- Sarwar, N.; Humayoun, U.; Kumar, M.; Zaidi, S.F.A.; Yoo, J.H.; Ali, N.; Jeong, D.I.; Lee, J.H.; Yoon, D.H. Citric acid mediated green synthesis of copper nanoparticles using cinnamon bark extract and its multifaceted applications. J. Clean. Prod. 2021, 292, 125974. [Google Scholar] [CrossRef]
- Saliem, A.H.; Abedsalih, A.N. Evaluation the antibacterial properties of different extracts of Cinnamomum zeylanicum barks. Adv. Anim. Vet. Sci. 2018, 6, 380–383. [Google Scholar] [CrossRef]
- Premkumar, J.; Sudhakar, T.; Dhakal, A.; Shrestha, J.B.; Krishnakumar, S.; Balashanmugam, P. Synthesis of silver nanoparticles (AgNPs) from cinnamon against bacterial pathogens. Biocatal. Agric. Biotechnol. 2018, 15, 311–316. [Google Scholar] [CrossRef]
- Jeevika, A.; Shankaran, D.R. Seed-free synthesis of 1D silver nanowires ink using clove oil (Syzygium Aromaticum) at room temperature. J. Colloid Interface Sci. 2015, 458, 155. [Google Scholar] [CrossRef]
- Su, H.; Huang, C.; Liu, Y.; Kong, S.; Wang, J.; Huang, H.; Zhang, B. Preparation and Characterization of Cinnamomum Essential Oil–Chitosan Nanocomposites: Physical, Structural, and Antioxidant Activities. Processes 2020, 8, 834. [Google Scholar] [CrossRef]
- de Oliveira, V.E.; Castro, H.; Edwards, H.G.M.; de Oliveira, L.F.C. Carotenes and carotenoids in natural biological samples: A Raman spectroscopic analysis. J. Raman Spectrosc. 2009, 41, 642–650. [Google Scholar] [CrossRef]
- Shokri, H. Evaluation of inhibitory effects of citric and tartaric acids and their combination on the growth of Trichophyton mentagrophytes, Aspergillus fumigatus, Candida albicans, and Malassezia furfur. Comp. Clin. Path. 2011, 20, 543–545. [Google Scholar] [CrossRef]
- Abdalla, K.H.; Al-Hannan, F.; Alghamdi, A.; Henari, F.Z. Green Synthesis of Silver Nanoparticles using Cinnamon (Cinnamomum cassia), Characterization andAntibacterial Activity. Int. J. Sci. Res 2017, 6, 665. [Google Scholar]
- Santhanam, A.; Kavitha, N.S.; Kumar, C.N. Synthesis and characterization of metal nanoparticles from the bark of Cinnamomum zeylanicum (Ceylon cinnamon). AIP Conf. Proc. 2019, 2115, 030108. [Google Scholar] [CrossRef]
- Sarwar, N.; Bin Humayoun, U.; Nawaz, A.; Yoon, D.H. Development of sustainable, cost effective foam finishing approach for cellulosic textile employing succinic acid/xylitol crosslinking system. Sustain. Mater. Technol. 2021, 30. [Google Scholar] [CrossRef]
- Sarwar, N.; Ashraf, M.; Mohsin, M.; Rehman, A.; Younus, A.; Javid, A.; Iqbal, K.; Riaz, S. Multifunctional Formaldehyde Free Finishing of Cotton by Using Metal Oxide Nanoparticles and Ecofriendly Cross-Linkers. Fibers Polym. 2019, 20, 2326–2333. [Google Scholar] [CrossRef]

| Sample Name | Description | Colonial Count | |
|---|---|---|---|
| S. aureus | E. coli | ||
| −tive control | Blank without any treatment | 3350 | 350 |
| +tive control | Fabric treated with cinnamon oil | 890 | 211 |
| Ag@CINN | Fabric treated with Ag@CINN | 248 | 119 |
| Ag@CINN-Lim | Fabric treated with Ag@CINN-Lim | 38 | 66 |
| Source | Medication | Reaction Time | Reference | |
|---|---|---|---|---|
| Cinnamon bark aqueous extract | No | 8 h | Long reaction time Nanoclusters Bioactivity not measured | [36] |
| Cinnamon bark aqueous extract | No | 2 days | Long reaction time Bioactivity against fungi is not measured | [37] |
| Cinnamon bark aqueous extract | No | 8 h | Long reaction time Bioactivity not measured | [42] |
| Cinnamon bark aqueous extract | Microwave | 1 day + microwave irradiation | Long reaction time High energy microwave utilization Bioactivity not measured | [43] |
| Clove oil | Acetone, NaOH | 100 °C at 30 min | Bioactivity against fungi is not measured | [30] |
| Cinnamon oil | Lime extract | Room temperature at 30 min | Quick reaction completion Bioactivity against both bacterial and fungi | Our work |
Disclaimer/Publisher’s Note: The statements, opinions and data contained in all publications are solely those of the individual author(s) and contributor(s) and not of MDPI and/or the editor(s). MDPI and/or the editor(s) disclaim responsibility for any injury to people or property resulting from any ideas, methods, instructions or products referred to in the content. |
© 2023 by the authors. Licensee MDPI, Basel, Switzerland. This article is an open access article distributed under the terms and conditions of the Creative Commons Attribution (CC BY) license (https://creativecommons.org/licenses/by/4.0/).
Share and Cite
Sarwar, N.; Zafar, M.S.; Humayoun, U.B.; Kim, S.; Ahmad, S.W.; Kim, Y.H.; Yoon, D.H. Citrous Lime—A Functional Reductive Booster for Oil-Mediated Green Synthesis of Bioactive Silver Nanospheres for Healthcare Clothing Applications and Their Eco-Mapping with SDGs. Molecules 2023, 28, 2802. https://doi.org/10.3390/molecules28062802
Sarwar N, Zafar MS, Humayoun UB, Kim S, Ahmad SW, Kim YH, Yoon DH. Citrous Lime—A Functional Reductive Booster for Oil-Mediated Green Synthesis of Bioactive Silver Nanospheres for Healthcare Clothing Applications and Their Eco-Mapping with SDGs. Molecules. 2023; 28(6):2802. https://doi.org/10.3390/molecules28062802
Chicago/Turabian StyleSarwar, Nasir, Muhammad Shahzad Zafar, Usama Bin Humayoun, Suhyeon Kim, Syed Waqas Ahmad, Yong Ho Kim, and Dae Ho Yoon. 2023. "Citrous Lime—A Functional Reductive Booster for Oil-Mediated Green Synthesis of Bioactive Silver Nanospheres for Healthcare Clothing Applications and Their Eco-Mapping with SDGs" Molecules 28, no. 6: 2802. https://doi.org/10.3390/molecules28062802
APA StyleSarwar, N., Zafar, M. S., Humayoun, U. B., Kim, S., Ahmad, S. W., Kim, Y. H., & Yoon, D. H. (2023). Citrous Lime—A Functional Reductive Booster for Oil-Mediated Green Synthesis of Bioactive Silver Nanospheres for Healthcare Clothing Applications and Their Eco-Mapping with SDGs. Molecules, 28(6), 2802. https://doi.org/10.3390/molecules28062802

